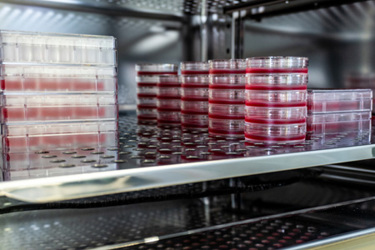
cell culture-GettyImages-1212712327

Vero Cell Culture In Corning® Dry Powder Vero Serum-free Medium
By C. Philip Harding, and Ann Rossi Bilodeau, Corning Incorporated, Life Sciences Kennebunk, ME USA
This study examined the effectiveness of Corning Vero Serum-free Medium in supporting the culture of adherent Vero cells. The chemically defined medium was compared to other commercially available pre-hydrated media. The results of this study showed that Vero cells adapted well to the Corning medium, with a higher average viability (~99%) and harvest yield during adaptation compared to other media (~96%). However, by Day 4, cell expansion in one of the competitive media had equaled that in the Corning medium, while the other competitor lagged. By Day 8, total Vero cell yields were highest for the first competitor, followed by Corning, and then the second competitor.
Get unlimited access to:
Enter your credentials below to log in. Not yet a member of Cell & Gene? Subscribe today.